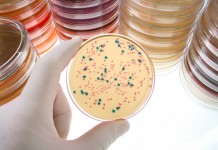

Архив
Сохранить грудь здоровой поможет Мастодинон®
Первыми признаками начинающейся мастопатии – заболевания груди – могут быть симптомы, которые многие женщины привыкли считать совершенно безобидными: тяжесть и набухание груди при ПМС,...
Зрачок расскажет о сексуальной ориентации
Американские ученые обнаружили, что сексуальную ориентацию можно определить по размеру зрачка. Сексуальная ориентация Существует три вида сексуальной ориентации: гетеросексуальность; гомосексуальность; ...
Что такое ПМС?
Многие женщины периодически ощущают небольшой дискомфорт, связанный с приближением менструации. Но у некоторых эти ощущения слишком сильны, тогда врачи ставят диагноз «предменструальный синдром» (ПМС)....
Никотин и внематочная беременность
Один из механизмов формирования внематочной беременности раскрыт. Британские ученые установили, почему курение приводит к внематочной беременности. Что такое внематочная беременность Внематочная беременность развивается в том случае,...
Какие механизмы помогают выносить беременность?
Американским ученым удалось ответить на давний вопрос, почему иммунная система матери не отторгает плод во время беременности. Работа иммунной системы В норме в ответ на появление...
В мире эпидемия гонореи! Достигнет ли она России?
Ежегодно в мире регистрируется около 106 миллионов случаев заболеваемости гонореей. По данным Всемирной организации здравоохранения (ВОЗ), возбудитель гонореи быстро приобретает устойчивость к современным антибиотикам....
Пять скрытых причин дрожжевой инфекции, или молочницы
Вас преследует неконтролируемый зуд в интимных местах? Возможно, вы столкнулись с неприятной грибковой инфекцией – молочницей, или, говоря научным языком, кандидозом. Грибки в норме присутствуют...
Оральная контрацепция и грудное вскармливание
Гормональная контрацепция – надежный способ защиты женщины во время грудного вскармливания. Однако нужно знать некоторые нюансы. При постановке вопроса об оральной контрацепции во время лактации...
Кожа женщины после 50 лет
Возраст 50 лет это полувековой юбилей и начало новой жизни женщины. Уход за кожей в этот период приобретает особое значение, и, если знать точно, что...
Я беременна?
Есть женщины, которые знают, что беременны уже через несколько дней: появляются необычные ощущения в теле. Но большинство из нас ничего не подозревает, пока не...